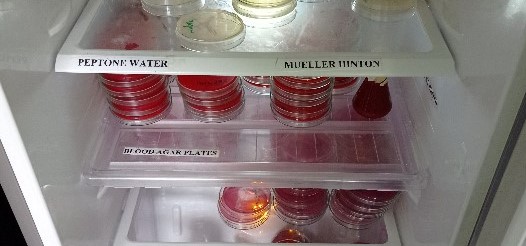
Image

The Ministry is committed to providing efficient and environmentally-friendly services to ensure sustainable and prosperous agriculture, livestock & fisheries sub-sectors.
| Serial No. | Service Offered | Client Requirement | Charges in (KSh) | Timelines |
|---|---|---|---|---|
| 1. | Customer Care | Nil | Free | Three (3) minutes of arrival |
| (a) Visitors' reception | ||||
| (b) Telephone calls | Nil | Free | Attended to within three rings | |
| (c) Correspondence | ||||
| 1. Letters | Nil | Free | Replied within 14 days from date of receipt. • Acknowledged within two days • Requested action to be taken within 14 days | |
| 2. Email | ||||
| (d) Technical correspondence | Nil | Free | Replied within 21 days of receipt of the enquiry. | |
| (e) Physical appearance | ||||
| 2. | Issuance of Licenses, permits and certificates | Adherence to application conditions | 0.50 to 5,000 | A maximum of 7 days |
| 3. | Provision of information on Agricultural sector credits, outputs/inputs and statistics | Formal request | Free | A maximum of 3 days |
| 4. | Provision of Agricultural sector information, education and communication | Formal request | Free | A maximum of 7 days |
| 5. | Provision of information on training opportunities and procedures | Formal request | Free | 1 month to deadline of application |
| 6. | Issuance of course approval | Application | Free | 1 month before course commence |
| 7. | Provision of attachments, internship and apprenticeship | Formal request | Free | One month |
| 8. | Disbursement of AIEs to stations & projects | None | Free | By 15 day of the start of quarter |
| 9. | Payment of Imprent & claim workers | Attach relevant documents | Free | 7 days |
| 10. | Procurement of goods and services | Attach relevant documents | Free | Depends on the nature of goods and services as per procurement regulations |
| 11. | Regular Ministry website content update | Web visit and feedback | Free | Weekly |
| 12. | Development of policy legislation, guidelines for implementation of agricultural sector programmes | On demand | Free | As need arises |
| 13. | Verification & recommendation of VAT and Custom Duty Exemptions/Waivers | Formal request | Free | 2 days |
| 14. | Monitoring and coordination of management of pests and disease outbreaks | Relevant/pertinent information | Free | One (1) week |
| 15. | Capacity building on cross-cutting practices by HIV/AIDS, gender, environment issues, NGOs and substance abuse | On demand | Free | One day to one month |
| 16. | Packaging and linking Agriculture Sector Statements with information on research and other service providers | On demand | Free | One day to two months |
| 17. | Provision of laboratory service | Sample | 0-1000 | 7 days |